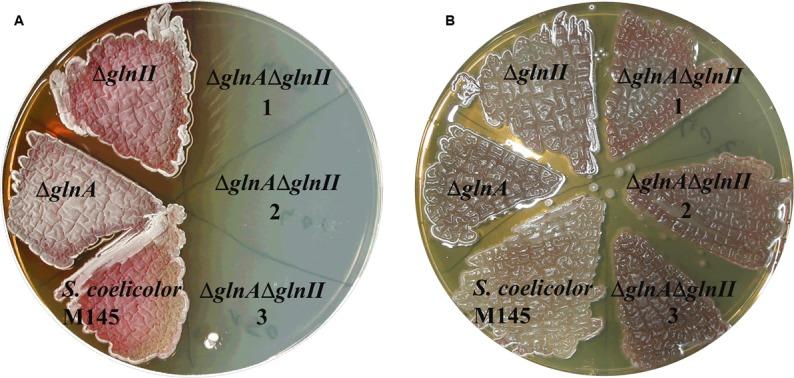

γ-谷氨酰多胺合成酶GlnA3参与M145中多胺降解途径的第一步。
Gamma-Glutamylpolyamine Synthetase GlnA3 Is Involved in the First Step of Polyamine Degradation Pathway in M145.
作者信息
Krysenko Sergii, Okoniewski Nicole, Kulik Andreas, Matthews Arne, Grimpo Jan, Wohlleben Wolfgang, Bera Agnieszka
机构信息
Interfaculty Institute of Microbiology and Infection Medicine Tübingen, Department of Microbiology and Biotechnology, University of TübingenTübingen, Germany.
出版信息
Front Microbiol. 2017 Apr 25;8:726. doi: 10.3389/fmicb.2017.00726. eCollection 2017.
M145 was shown to be able to grow in the presence of high concentrations of polyamines, such as putrescine, cadaverine, spermidine, or spermine, as a sole nitrogen source. However, hardly anything is known about polyamine utilization and its regulation in streptomycetes. In this study, we demonstrated that only one of the three proteins annotated as glutamine synthetase-like protein, GlnA3 (SCO6962), was involved in the catabolism of polyamines. Transcriptional analysis revealed that the expression of was strongly induced by exogenous polyamines and repressed in the presence of ammonium. The Δ mutant was shown to be unable to grow on defined Evans agar supplemented with putrescine, cadaverine, spermidine, and spermine as sole nitrogen source. HPLC analysis demonstrated that the Δ mutant accumulated polyamines intracellularly, but was unable to degrade them. In a rich complex medium supplemented with a mixture of the four different polyamines, the Δ mutant grew poorly showing abnormal mycelium morphology and decreased life span in comparison to the parental strain. These observations indicated that the accumulation of polyamines was toxic for the cell. An analysis of the GlnA3 protein model suggested that it might act as a gamma-glutamylpolyamine synthetase catalyzing the first step of polyamine degradation. GlnA3-catalyzed glutamylation of putrescine was confirmed in an enzymatic assay and the GlnA3 reaction product, gamma-glutamylputrescine, was detected by HPLC/ESI-MS. In this work, the first step of polyamine utilization in has been elucidated and the putative polyamine utilization pathway has been deduced based on the sequence similarity and transcriptional analysis of homologous genes expressed in the presence of polyamines.
已证明M145能够在高浓度多胺(如腐胺、尸胺、亚精胺或精胺)作为唯一氮源的情况下生长。然而,关于链霉菌中多胺的利用及其调控,人们几乎一无所知。在本研究中,我们证明,在三种被注释为谷氨酰胺合成酶样蛋白的蛋白质中,只有GlnA3(SCO6962)参与了多胺的分解代谢。转录分析表明,其表达受到外源多胺的强烈诱导,并在有铵存在的情况下受到抑制。Δ突变体被证明无法在添加腐胺、尸胺、亚精胺和精胺作为唯一氮源的限定伊文斯琼脂上生长。高效液相色谱分析表明,Δ突变体在细胞内积累了多胺,但无法降解它们。在添加了四种不同多胺混合物的丰富复合培养基中,与亲本菌株相比,Δ突变体生长不良,表现出异常的菌丝形态和缩短的寿命。这些观察结果表明,多胺的积累对细胞有毒。对GlnA3蛋白模型的分析表明,它可能作为γ-谷氨酰多胺合成酶催化多胺降解的第一步。在酶促测定中证实了GlnA3催化的腐胺谷氨酰化反应,并通过高效液相色谱/电喷雾质谱检测到了GlnA3反应产物γ-谷氨酰腐胺。在这项工作中,已阐明了链霉菌中多胺利用的第一步,并基于多胺存在时表达的同源基因的序列相似性和转录分析推导了推测的多胺利用途径。